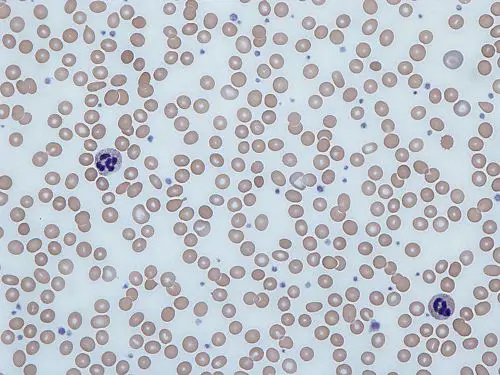

10 Interesting Anemia Facts
Anemia as the most common health disorder can disturb daily routines, if you did not aware the causal effect of it. Here are the facts of anemia, which can be interesting to understand:
Anemia Facts 1: iron deficiency
Anemia is a condition of a deficiency of red cell or hemoglobin in the blood. The cause of this condition can be several depend on personality background, immunity, lifestyle or genetics. Generally, anemia can be happen because of blood disorder
Anemia Facts 2: types of anemia
Generally, the types of anemia can be divided into two types, size of the red cells such as microcytic, macrocytic, normocytic anemia. Based on the causal facts it can be divided to hemolytic and nutritional anemia.
Anemia Facts 3: cause
Several causes such as blood loss, diet, pregnancy, iron absorption. The most commonly know is because of lack nutrition.
Anemia Facts 4: mild signs and symptoms
Signs and symptoms of Anemia are quite hard to discover in the early stage because it is quite mild and usual. Its include anxiety, irritability, sleepiness, fainting, depressions, breathlessness, palpitation hair loss, poor appetite dizziness, headache etc. Get facts about whopping cough here.
Anemia Facts 5: blood test as prevention
Doing routines blood test is the best prevention to detect anemia if it is just related to the lack of nutrion or others dangerous type.
Anemia Facts 6: lifestyle
Lifestyle contribute hardly to the cause of anemia, whether its health or not. Working too hard, wrong diet, malnutrition are the supporting factors related to the iron deficiency.
Anemia Facts 7: supplement and healthy diet
Food supplement after consulting it with the doctor will almost help. The most important is the healthy diet of foods, which contains high iron like these super food for anemia such as tomatoes, spinach, pomegranate, sesame seeds, parsley, dates and raisins. The things you eat will bring the most contribution through your health whether it is good or not, junk food is a big no. Look at facts about swine flu here.
Anemia Facts 8: stress
Stress bring the great chance develop anemia. Mental stress and tension long term emotional have a huge impact of the body’s organ especially the spleen and liver. Having plenty of good sleep is very crucial to beat stress. Therefore, better to always find little time to relax and play just to relieve yourself of all the stress of work.
Anemia Facts 9: who is at risk?
Women, young and pregnant are have the highest risk of developing this condition. The monthly menstrual cycle can explain this blood loss during menstruation. The pregnant women also at the risk due to low levels of folic acid (folate) and low level of iron change in the blood during the pregnancies.
Anemia Facts 10: beat naturally
Beat anemia naturally by thinking positive to reduce stress, choosing healthy nutrition, lifestyle changes, and diet changes. That factor will help a lot to prevent anemia and talking to a medical professional is important to make accurate diagnosis.
You can beat anemia naturally right. Are you interested reading anemia facts?